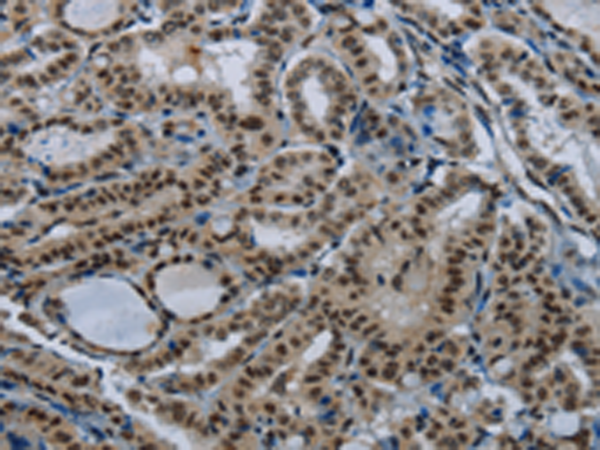

中文名稱: 兔抗NBL1多克隆抗體
英文名稱: Anti-NBL1 rabbit polyclonal antibody
別 名: NB; DAN; NO3; DAND1; D1S1733E
相關(guān)類別: 一抗
儲(chǔ) 存: 冷凍(-20℃)
宿 主: Rabbit
抗 原: NBL1
反應(yīng)種屬: Human, Mouse, Rat
標(biāo) 記 物: Unconjugate
克隆類型: rabbit polyclonal
技術(shù)規(guī)格
|
Background: |
This gene product is the founding member of the evolutionarily conserved CAN (Cerberus and DAN) family of proteins, which contain a domain resembling the CTCK (C-terminal cystine knot-like) motif found in a number of signaling molecules. These proteins are secreted, and act as BMP (bone morphogenetic protein) antagonists by binding to BMPs and preventing them from interacting with their receptors. They may thus play an important role during growth and development. |
|
Applications: |
ELISA, IHC |
|
Name of antibody: |
NBL1 |
|
Immunogen: |
Fusion protein of human NBL1 |
|
Full name: |
neuroblastoma 1, DAN family BMP antagonist |
|
Synonyms: |
NB; DAN; NO3; DAND1; D1S1733E |
|
SwissProt: |
P41271 |
|
ELISA Recommended dilution: |
2000-5000 |
|
IHC positive control: |
Human thyroid cancer |
|
IHC Recommend dilution: |
50-200 |
購(gòu)物車
幫助
021-54845833/15800441009
